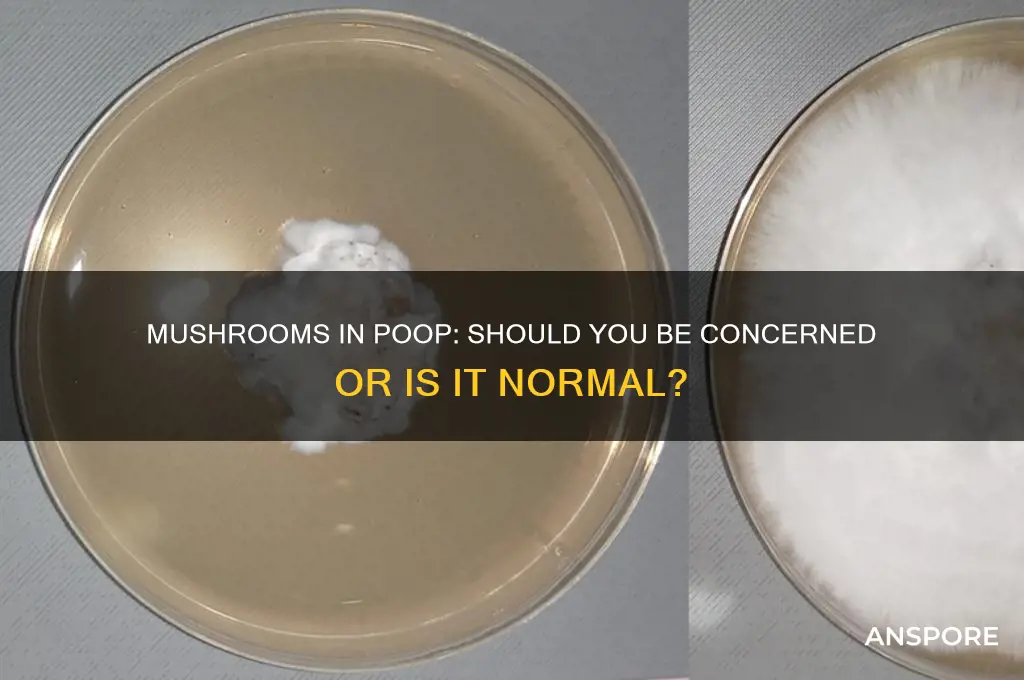
is it normal to have mushrooms in poop

The presence of mushrooms in poop can be a startling and concerning discovery, leaving many to wonder if it’s a normal occurrence or a sign of an underlying issue. While it’s uncommon, mushrooms in stool can result from consuming mushroom-based foods or supplements that pass through the digestive system undigested. However, in rare cases, it could indicate a fungal infection or overgrowth in the gut, particularly in individuals with weakened immune systems or those taking certain medications. If you notice mushrooms in your poop and are unsure of the cause, consulting a healthcare professional is advisable to rule out any potential health concerns.
| Characteristics | Values |
|---|---|
| Normal Occurrence | Not normal; presence of mushrooms in stool is rare and unusual |
| Possible Causes | Ingestion of mushroom-rich foods, fungal overgrowth (e.g., Candida), or parasitic infections |
| Health Implications | May indicate underlying gastrointestinal issues, dietary factors, or infections |
| Visible Appearance | Small, white, or brown mushroom-like structures in stool |
| Medical Advice | Consult a healthcare professional if mushrooms are observed in stool, as it may require evaluation |
| Related Conditions | Fungal infections (e.g., Candida), gut dysbiosis, or dietary sensitivities |
| Diagnostic Tests | Stool analysis, fungal cultures, or endoscopic evaluation may be recommended |
| Treatment Options | Antifungal medications, dietary modifications, or addressing underlying conditions |
| Prevention | Maintain a balanced diet, avoid excessive mushroom consumption, and practice good hygiene |
| Frequency | Extremely rare; not a typical finding in healthy individuals |
Explore related products
What You'll Learn
- Dietary Causes: Certain foods like mushrooms or fungi-rich items can appear in stool
- Digestive Health: Undigested food particles in poop may indicate digestion issues
- Fungal Infections: Conditions like Candida overgrowth can cause visible fungi in stool
- Environmental Factors: Accidental ingestion of mold or mushrooms might show in poop
- Medical Concerns: Persistent fungi in stool warrants consultation with a healthcare professional

Dietary Causes: Certain foods like mushrooms or fungi-rich items can appear in stool
It's not uncommon for people to notice unusual substances in their stool, and the presence of mushrooms or fungi-rich items can be a cause for concern. However, in many cases, this phenomenon can be attributed to dietary causes. When we consume certain types of food, especially those rich in fungi or mushrooms, it's possible for remnants of these foods to appear in our stool. This is because our digestive system may not fully break down the tough cell walls of mushrooms and other fungi, allowing them to pass through the digestive tract relatively intact. As a result, small pieces of mushrooms or fungi-rich items can be visible in the stool, which might be alarming but is often harmless.
Dietary causes of mushrooms in poop are typically linked to the consumption of mushrooms themselves or foods that contain mushroom extracts. For instance, eating a mushroom-heavy meal, such as a mushroom risotto or a pizza with mushroom toppings, can lead to visible mushroom fragments in the stool. Similarly, consuming fungi-rich foods like tempeh, miso, or certain types of fermented foods can also contribute to this occurrence. It's essential to note that the presence of mushrooms in stool due to dietary causes is usually temporary and resolves on its own once the food has passed through the system. If you've recently consumed a meal rich in mushrooms or fungi, it's likely that the mushrooms in your poop are a direct result of that meal.
In addition to whole mushrooms, certain processed foods and supplements can also contain mushroom or fungal components that may appear in stool. For example, some protein powders, energy bars, or dietary supplements are fortified with mushroom extracts, such as reishi or chaga, for their purported health benefits. When consumed in large quantities or by individuals with sensitive digestive systems, these supplements can sometimes lead to visible fungal remnants in the stool. Furthermore, foods like mushroom-based sauces, soups, or even mushroom-infused coffee can contribute to this phenomenon. Being mindful of your diet and keeping track of the foods you consume can help you identify the source of mushrooms in your poop and determine whether it's a cause for concern.
It's worth mentioning that not all mushrooms or fungi-rich foods will necessarily appear in stool, as individual digestive systems can vary significantly. Factors such as gut transit time, enzyme production, and gut microbiome composition can influence how well our bodies break down and absorb these foods. In some cases, people with slower gut transit times or conditions like irritable bowel syndrome (IBS) might be more prone to noticing undigested food particles, including mushrooms, in their stool. If you consistently observe mushrooms in your poop and are concerned about your digestive health, it's advisable to consult a healthcare professional or registered dietitian to discuss your symptoms and dietary habits.
While dietary causes are a common explanation for mushrooms in poop, it's crucial to differentiate this from other potential underlying issues. In rare cases, the presence of mushrooms or fungal elements in stool could be indicative of a gastrointestinal infection or an overgrowth of fungi in the gut. However, these situations are typically accompanied by other symptoms, such as abdominal pain, diarrhea, or changes in stool consistency. If you experience persistent or severe symptoms, or if the mushrooms in your poop are accompanied by other concerning signs, it's essential to seek medical advice to rule out any underlying conditions and receive appropriate treatment.
Petrified Mushrooms: Nature's Rare Wonders
You may want to see also

Digestive Health: Undigested food particles in poop may indicate digestion issues
While the presence of mushrooms in stool is not a common concern, the broader topic of undigested food particles in poop is an important aspect of digestive health. It is not unusual to occasionally notice small fragments of food in your stool, but frequent or significant amounts of undigested material may signal underlying digestion issues. The digestive system is responsible for breaking down food into nutrients that can be absorbed by the body, and any disruption in this process can lead to incomplete digestion. When food passes through the digestive tract too quickly or when digestive enzymes and acids are insufficient, it can result in undigested particles appearing in the stool.
One of the primary reasons for undigested food in poop is poor chewing. The digestive process begins in the mouth, where saliva and mechanical action break down food into smaller pieces. If food is not chewed thoroughly, larger particles enter the stomach and intestines, making it harder for digestive enzymes to do their job. This can lead to chunks of food, such as vegetables or fibers, appearing in the stool. To improve this, it’s essential to practice mindful eating, taking time to chew food properly and allowing the digestive process to start effectively.
Another common cause of undigested food particles is a lack of digestive enzymes or stomach acid. Conditions like exocrine pancreatic insufficiency (EPI) or hypochlorhydria (low stomach acid) can impair the breakdown of food, particularly fats, proteins, and carbohydrates. For instance, undigested fat may appear as greasy or oily stool, while undigested carbohydrates can manifest as visible pieces of vegetables, grains, or seeds. If you suspect enzyme or acid deficiency, consulting a healthcare provider for testing and potential supplementation may be necessary.
Food intolerances or sensitivities can also contribute to undigested food in poop. For example, individuals with lactose intolerance may notice undigested dairy products in their stool because their bodies lack the enzyme lactase to break down lactose. Similarly, those with gluten sensitivity or celiac disease might see undigested grains in their poop due to impaired nutrient absorption. Keeping a food diary and identifying trigger foods can help manage these conditions and improve digestive health.
Lastly, certain gastrointestinal disorders, such as irritable bowel syndrome (IBS) or inflammatory bowel disease (IBD), can cause rapid transit of food through the digestive tract, leading to undigested particles in the stool. These conditions often require medical intervention, including dietary changes, medications, or therapies to address the underlying issues. Monitoring your stool consistency and content can provide valuable insights into your digestive health, prompting timely intervention if abnormalities persist.
In summary, while finding mushrooms in poop is not a typical concern, undigested food particles in stool can indicate digestion issues that warrant attention. Proper chewing, addressing enzyme or acid deficiencies, managing food intolerances, and treating gastrointestinal disorders are key steps to improving digestive health. If you consistently notice undigested food in your stool, it’s advisable to consult a healthcare professional for a thorough evaluation and personalized guidance.
Shared Roots: Exploring the Ancient Link Between Humans and Mushrooms
You may want to see also

Fungal Infections: Conditions like Candida overgrowth can cause visible fungi in stool
While finding mushrooms in your poop might sound alarming, it’s important to understand that what you’re likely seeing isn’t actually mushrooms, but rather symptoms of a fungal infection, most commonly Candida overgrowth. Candida is a type of yeast that naturally resides in the human gut in small amounts. However, when it overgrows, it can lead to visible changes in stool, including white, stringy, or clumpy material that might be mistaken for mushrooms. This condition, known as candidiasis, can disrupt the balance of your gut microbiome and manifest in various ways, including alterations in bowel movements.
Candida overgrowth occurs when the natural balance of microorganisms in the gut is disrupted, often due to factors like antibiotic use, a high-sugar diet, weakened immune system, or hormonal changes. When Candida proliferates unchecked, it can lead to systemic issues, including gastrointestinal symptoms. Visible fungi in stool is one such symptom, as the excess yeast can be expelled through the digestive tract. This may appear as white patches or strands in the stool, which could be misinterpreted as mushrooms. It’s crucial to differentiate this from actual mushrooms, as the latter would indicate ingestion of fungal material rather than an infection.
If you suspect Candida overgrowth, it’s essential to consult a healthcare professional for an accurate diagnosis. Symptoms often accompany visible changes in stool, such as bloating, gas, abdominal pain, fatigue, and even skin issues like rashes. A healthcare provider may recommend tests like stool analysis, blood tests, or a Candida antibody test to confirm the diagnosis. Treatment typically involves antifungal medications, dietary changes to reduce sugar and refined carbohydrates, and probiotics to restore gut flora balance. Addressing the root cause, such as discontinuing unnecessary antibiotics or managing underlying health conditions, is also critical.
Preventing Candida overgrowth involves maintaining a healthy lifestyle that supports gut health. This includes eating a balanced diet rich in fiber, lean proteins, and healthy fats while minimizing processed foods and sugars that feed yeast. Probiotic-rich foods like yogurt, kefir, and fermented vegetables can also help maintain a healthy gut microbiome. Additionally, staying hydrated, managing stress, and ensuring adequate sleep can strengthen your immune system and reduce the risk of fungal infections. If you notice persistent changes in your stool or other symptoms, don’t ignore them—early intervention can prevent complications and restore your gut health.
In summary, while it’s not normal to have mushrooms in your poop, visible fungi in stool can be a sign of Candida overgrowth or other fungal infections. These symptoms should not be dismissed, as they indicate an imbalance in your gut microbiome that requires attention. By understanding the causes, recognizing the symptoms, and seeking appropriate treatment, you can address the issue effectively and maintain optimal digestive health. Always consult a healthcare professional for a proper diagnosis and tailored treatment plan.
Dried vs Fresh Mushrooms: Equivalent Ratios Explained
You may want to see also
Explore related products

Environmental Factors: Accidental ingestion of mold or mushrooms might show in poop
It's important to understand that finding mushrooms or mold in your stool is not a typical occurrence and could be a cause for concern. While the human digestive system is designed to process a wide variety of foods, the presence of fungi in the gut is generally not considered normal. However, there are environmental factors that can lead to the accidental ingestion of mold or mushrooms, which may result in their appearance in your poop. One common scenario is consuming food that has been contaminated with mold. This can happen with bread, fruits, or vegetables that have been stored improperly or left out for too long. Mold spores are microscopic and can be present on food without being visible to the naked eye, making it easy to ingest them unknowingly.
Another environmental factor is the consumption of wild mushrooms. Foraging for mushrooms has become a popular activity, but it carries risks. Many wild mushrooms resemble edible varieties but are toxic or contain compounds that can cause digestive issues. If you've recently eaten wild mushrooms, especially if you're unsure of their identification, their remnants might appear in your stool. This is a clear indication of accidental ingestion and should prompt a review of your recent dietary choices. It's crucial to properly identify mushrooms before consumption, as some species can cause severe health problems.
##
Living in damp or humid environments can also increase the likelihood of ingesting mold spores. Mold thrives in such conditions and can grow on various surfaces, including walls, ceilings, and even furniture. Inhaling mold spores is common in these environments, and while the body can often eliminate them, some may pass through the digestive system, potentially appearing in stool samples. This is particularly relevant for individuals with mold allergies or sensitivities, as their bodies may react more noticeably to the presence of mold.
Furthermore, certain occupational hazards can contribute to the accidental ingestion of fungi. Farmers, gardeners, and individuals working with organic materials are at a higher risk of inhaling or ingesting mold spores and mushroom fragments. These particles can become airborne during various activities, such as harvesting crops, handling soil, or cleaning moldy surfaces. Over time, repeated exposure can lead to a buildup of fungal matter in the body, which may be excreted in the stool.
It's worth noting that while these environmental factors can lead to mushrooms or mold in your poop, it is not a common or healthy occurrence. If you notice this consistently or experience any digestive issues, it is advisable to consult a healthcare professional. They can provide guidance on dietary adjustments, environmental changes, or medical interventions to address the root cause and ensure your digestive health. Understanding these environmental factors is the first step in preventing and managing such unusual stool occurrences.
Pom Pom Mushrooms: Nature's Fluffy Delights
You may want to see also

Medical Concerns: Persistent fungi in stool warrants consultation with a healthcare professional
While the presence of occasional fungal elements in stool can be normal, persistent or noticeable mushrooms in poop should raise medical concerns. Fungi are ubiquitous in the environment, and trace amounts can naturally occur in the gastrointestinal tract without causing harm. However, visible mushrooms or recurrent fungal presence in stool may indicate an underlying issue that requires professional evaluation. This is particularly important because the gastrointestinal system is a complex ecosystem, and disruptions can lead to serious health complications if left unaddressed.
Persistent fungi in stool could be a sign of an overgrowth of yeast or mold in the gut, such as *Candida* species, which can thrive under certain conditions like antibiotic use, a weakened immune system, or dietary imbalances. While *Candida* is a normal part of gut flora, its overgrowth can lead to symptoms like bloating, diarrhea, abdominal pain, and fatigue. In severe cases, systemic fungal infections may occur, especially in immunocompromised individuals. Therefore, consulting a healthcare professional is essential to determine the cause and severity of the fungal presence.
Another medical concern is the possibility of ingesting fungi through contaminated food or water, which could manifest as mushrooms in stool. Certain types of mushrooms or molds can be toxic and cause gastrointestinal distress, liver damage, or other systemic issues. A healthcare provider can assess whether the fungi in the stool are related to dietary intake and recommend appropriate measures, such as dietary adjustments or treatment for potential poisoning. Ignoring this issue could lead to prolonged discomfort or more serious health risks.
Furthermore, persistent fungi in stool may be linked to underlying gastrointestinal disorders, such as inflammatory bowel disease (IBD), irritable bowel syndrome (IBS), or malabsorption syndromes. These conditions can alter the gut environment, making it more hospitable for fungal growth. A healthcare professional can conduct diagnostic tests, such as stool analysis, blood tests, or endoscopy, to identify the root cause and develop a targeted treatment plan. Early intervention is crucial to prevent complications and improve quality of life.
Lastly, individuals with persistent fungi in their stool should not attempt self-diagnosis or treatment without medical guidance. Over-the-counter antifungal medications or dietary supplements may not address the underlying issue and could exacerbate the problem. A healthcare professional can provide a comprehensive assessment, considering factors like medical history, lifestyle, and potential environmental exposures. They can then recommend evidence-based treatments, such as prescription antifungals, probiotics, or dietary modifications, tailored to the individual’s needs. Persistent fungi in stool are not a condition to be taken lightly, and timely consultation with a healthcare provider is imperative for proper management and resolution.
The Mystery of Manna: Mushroom or Miracle?
You may want to see also
Frequently asked questions
No, it is not normal to have mushrooms in poop. Mushrooms in stool could indicate ingestion of fungal material or a rare infection, and should be evaluated by a healthcare professional.
Mushrooms in poop may result from consuming mushrooms or foods contaminated with fungal spores. In rare cases, it could be linked to a fungal infection in the digestive tract.
Yes, seeing mushrooms in your poop is unusual and warrants medical attention. Consult a doctor to rule out infections, dietary causes, or other underlying health issues.











































